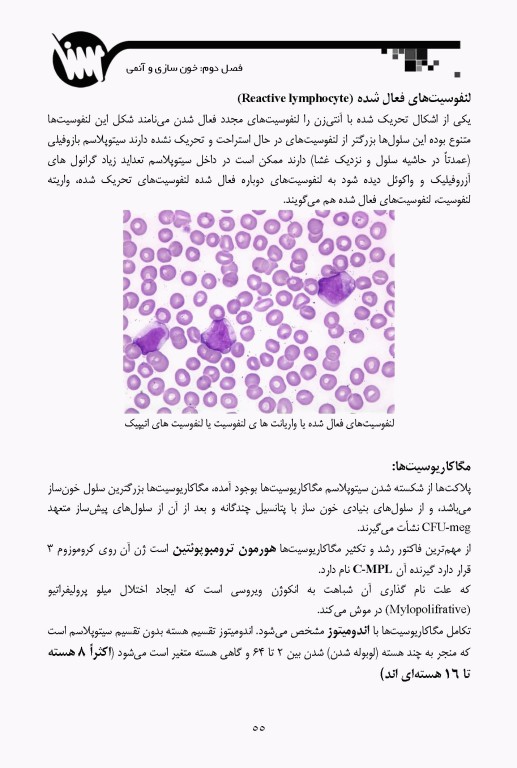
خون‌شناسی و بانک خون

کتاب خونشناسی و بانک خون تالیف مریم قیدی شهران و مهنوش عباسزاده دیباور توسط انتشارات سنا (سلول) به چاپ رسیده است. این کتاب، درسنامهای جامع از مطالب خونشناسی و بانک خون است که براساس بهروزترین مراجع معرفی شده وزارت بهداشت به صورت مجموعهای فشرده در کنار یکدیگر جمع آوری شدهاند.
این کتابُ به بررسی مباحثی چون کلیات خونشناسی، نحوه خونسازی در بدن و همچنین، علت و علائم آنمی (کم خونی)، اختلالات و بیماریهایی که منشا خونی دارند و بررسی ساختمانهای پلاکتها و گلبولهای خون میپردازد.
درسنامه خونشناسی و بانک خون میتواند به عنوان گنجینهای مطالعاتی در زمینه خونشناسی آزمایشگاهی و بانک خون برای دانشجویان و داوطلبان کارشناسی ارشد رشته علوم آزمایشگاهی مورد استفاده قرار گیرد.
ویژگیهای کتاب
- درسنامه جامع و پایه خونشناسی و بانک خون
- متنی روان و ساده مناسب برای دانشجویان و داوطلبان
- شامل پنج فصل کاربردی در زمینه کلیات خونشناسی
- منبع مناسب دانشجویان رشتههای علوم آزمایشگاهی، پزشکی، پرستاری و رشتههای مرتبط